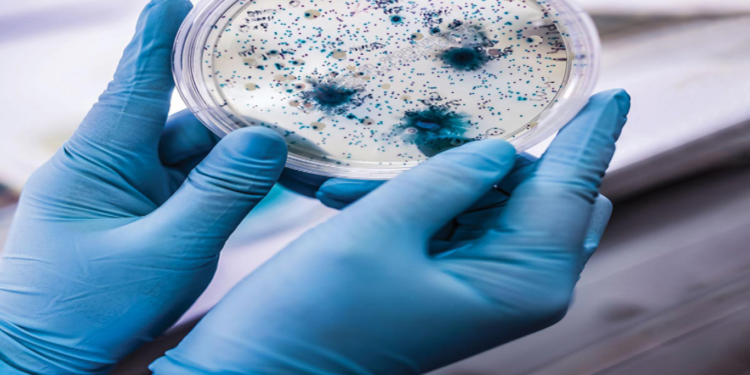

الحمل الميكروبي أحد العوامل المؤثره على معدلات الجودة، والتي تنعكس بدورها على حجم المردود والعائد الاقتصادي، الذي يجنيه المزارع في نهاية الموسم، ما يستدعي تسليط الضوء عليه والتوعية بخطورته، والالتزام بالتوصيات الفنية الواردة بهذا الشأن، بما يُعزز حجم المكاسب والأرباح والجودة وصولًا إلى مستوياتها المثلى.
وخلال حلوله ضيفًا على الإعلامي طه اليوسفي، مُقدم برنامج “المرشد الزراعي”، المُذاع عبر شاشة قناة مصر الزراعية، تناول الدكتور حسام محيسن – نائب رئيس قسم النباتات الطبية والعطرية، مركز البحوث الزراعية – ملف الحمل الميكروبي وتأثيره السلبي على مُعدلات جودة المحصول بالشرح والتحليل، مُسلطًا الضوء على أهم الخطوات التي يُمكن اتخاذها للتغلب على هذه الإشكالية وتخطيها بالشكل العلمي الصحيح.
الحمل الميكروبي.. ملاحظات ألمانية على المزارع المصري
في البداية تحدث الدكتور حسام محيسن عن أبرز النقاط السلبية التي رصدتها الجهات البحثية الألمانية، القائمة على فحص الشحنات التي يتم استيرادها منا، والتي دار مُعظمها حول ارتفاع الحمل الميكروبي لها، بسبب بعض الممارسات الخاطئة التي يقع فيها المزارعين.
أبرز الممارسات الخاطئة التي يقع فيها المزارعين
رصد نائب رئيس قسم النباتات الطبية والعطرية عددًا من الممارسات اليومية الخاطئة التي يقع فيها بعض المزارعين، والتي تؤدي بالتبعية لزيادة الحمل الميكروبي وتخطيه للنسب القياسية المسموحة هناك، والتي يمكن تلخيصها في النقاط التالية:
1. عدم الاعتناء بالنظافة الشخصية
2. النزول إلى الحقل أثناء المرض أو الاستعانة بعمالة تحمل بعض المُسببات المرضية
3. عدم تخصيص زي مُعين للزراعة والحقل
4. إهمال تعقيم الأيدي والأدوات المُستخدمة خلال الزراعة
5. عدم ارتداء واقي اليد
6. الاستعانة بمياه الصرف المُلوثة وغير المُعالجة في ري المحاصيل
5 حلول إجرائية للحيلولة دون ارتفاع الحمل الميكروبي
لفت “محيسن” إلى بعض الإجراءات التي تم اتخاذها للتغلب على هذه الإشكاليات، التي تدعم فُرص زيادة الحمل الميكروبي في المحصول، والتي أوجزها في النقاط التالية:
1. تخصيص زي مُعين للأعمال الزراعية والحقلية مع غسلها وتعقيمها بشكل منتظم
2. ارتداء واقي اليد “جوانتي”
3. تعقيم اليد بالمطهرات المناسبة “كحول” أو الملح حال عدم وجودها
4. عدم النزول إلى الحقل أثناء الشعور بأي أعراض مرضية
5. مداومة غسيل اليد وتطهير الأدوات المُستخدمة
لفت أستاذ مركز البحوث الزراعية إلى أن التزام المزارعين بتنفيذ هذه الخطوات، هبط بمعدلات الحمل الميكروبي خلال فترة زمنية قياسية، من 8 مليون خلية/الجرام، إلى 4 آلاف خلية ميكروبية فقط، وهو رقم مُرضي ومقبول إلى حد كبير.
موضوعات قد تهمك
جفاف حجر القطن.. أسباب الإصابة وأفضل توقيت لرش المبيدات “الحبيبية والسائلة”
مكافحة دودة الحشد “قبل الزراعة”.. 4 خطوات لحماية “الذرة” من الإصابة
الحيازات الزراعية الصغيرة.. أبرز معوقات التصدير
انتقل “محيسن” إلى نقطة بالغة الأهمية، وهي الخاصة بأحد أبرز مُشكلات المُزارعين، والتي تؤثر بالتبعية على فُرص التصدير، وأبرزها تفتت الحيازات الزراعية إلى مساحات صغيرة، ما يؤدي لعدم إمكانية تطبيق برامج زراعية مُنضبطة، والتركيز على محصول بعينه لطرق أبواب التصدير.
وهي النقطة الثانية التي رصدتها الجهات الألمانية المعنية بمتابعة الصادرات المصرية، بوصفها أحد مُعوقات تحقيق المواصفات القياسية المطلوبة، في الشحنات الواردة إليهم، لافتًا إلى أن هذه الإشكالية يُمكن التغلب عليها، بضم هذه المساحات الصغيرة، وتحويلها لكيان واحد ضخم، يلتزم بتطبيق ذات البرامج والمعاملات الفنية، للوصول لأفضل إنتاجية مُمكنة.
إقرأ أيضًا
الذرة الشامية.. “7” توصيات فنية وأفضل الهُجن للزراعات المتأخرة
محصول الطماطم.. أسباب موت البذور والشتلات وركائز خطة العلاج “الخماسية”
شاهد